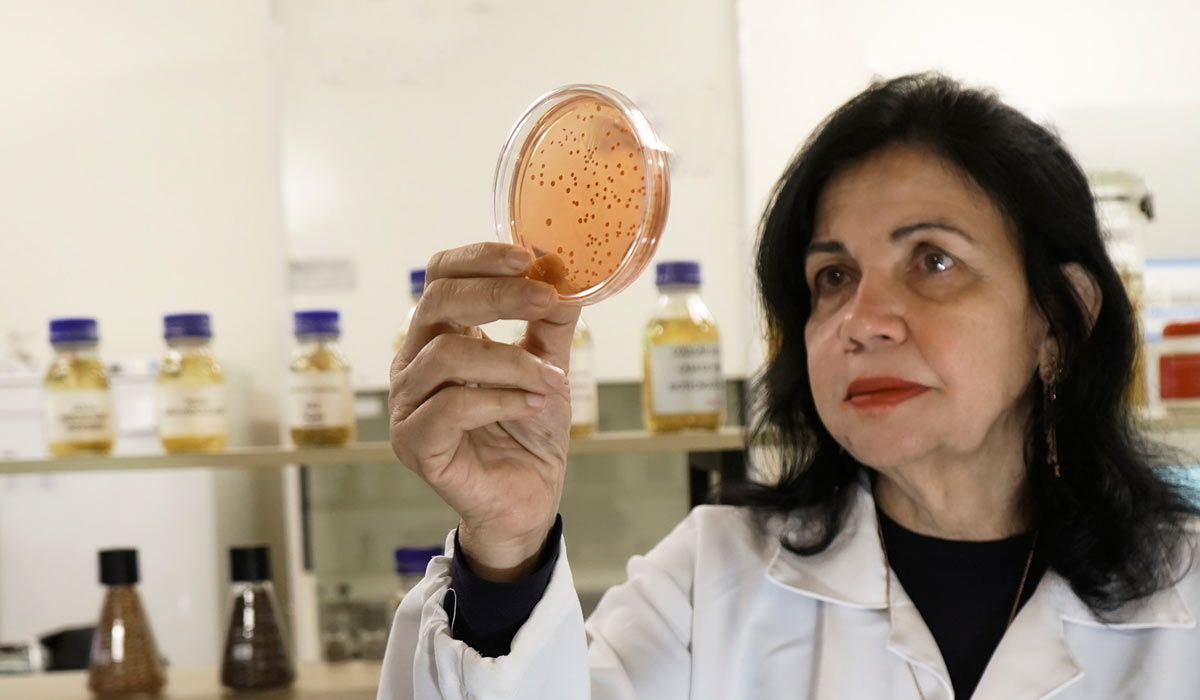
Mariangela Hungria lidera avanços em biológicos no campo Mariangela Hungria lidera avanços em biológicos no campo

Ciência nacional ganha destaque entre os mais influentes do mundo, reconhecimento que reflete uma mudança global de percepção, com maior valorização de práticas sustentáveis e da produção de alimentos mais saudáveis
A inclusão da pesquisadora Mariangela Hungria da Cunha na lista Time 100 de 2026, na categoria Pioneiros, representa um marco institucional relevante para a ciência agrária brasileira. A seleção, promovida pela revista Time, reconhece as 100 pessoas mais influentes do mundo, destacando impacto, inovação e conquistas. No contexto do agronegócio, trata-se de uma legitimação internacional de tecnologias baseadas em insumos biológicos na agricultura, que vêm reposicionando o Brasil como protagonista em produção sustentável de alimentos em larga escala.
A repercussão do reconhecimento ultrapassa a dimensão individual e projeta o papel da Embrapa como centro de excelência em pesquisa aplicada. Ao destacar que o prêmio reflete um esforço coletivo, a pesquisadora reforça a natureza sistêmica da inovação agrícola, baseada no trabalho científico desenvolvido na Embrapa, especialmente na área de substituição de produtos químicos por biológicos. Esse modelo tem sido fundamental para acelerar a difusão de tecnologias que conciliam produtividade agrícola e sustentabilidade ambiental, especialmente em sistemas tropicais.
Sob a ótica estratégica, o reconhecimento também sinaliza uma mudança global de percepção, com maior valorização de práticas sustentáveis e da produção de alimentos mais saudáveis. Há uma crescente valorização de sistemas produtivos alinhados ao conceito de saúde única (One Health), que integra saúde do solo, das plantas, dos animais e das pessoas. Nesse cenário, o Brasil passa a ser observado como líder em soluções tecnológicas baseadas em biotecnologia e microbiologia do solo, com potencial de expansão global.
Trajetória científica e formação de uma liderança em microbiologia do solo
Nascida em 06 de fevereiro de 1958, em São Paulo, e criada em Itapetinga (SP), Mariangela Hungria demonstrou desde cedo interesse por temas relacionados à terra, água e ar. Sua decisão de seguir carreira científica foi influenciada pela leitura do livro “Caçadores de Micróbios”, de Paul de Kruif, despertando o interesse pela microbiologia aplicada ao solo e às plantas, área na qual viria a se tornar uma das maiores referências mundiais.

fortalece competitividade do agronegócio som
solo saudável como base da produção agrícola
Graduada em Engenharia Agronômica pela Esalq/USP, com mestrado em Solos e Nutrição de Plantas e doutorado em Ciência do Solo pela UFRRJ, sua trajetória acadêmica foi marcada por forte base científica. Um ponto decisivo foi a influência da pesquisadora Johanna Döbereiner, pioneira na fixação biológica de nitrogênio (FBN). Essa mentoria consolidou a orientação de Hungria para soluções sustentáveis baseadas em processos biológicos, com foco na eficiência nutricional das plantas.
Desde 1982 na Embrapa, inicialmente na unidade de Agrobiologia e, desde 1991, na Embrapa Soja, em Londrina, Hungria desenvolveu uma produção científica expressiva. São mais de 500 publicações científicas, além da orientação de mais de 200 alunos. Essa atuação contribui diretamente para a formação de especialistas em microbiologia agrícola e biotecnologia, ampliando o impacto da pesquisa brasileira no cenário internacional.
Inovações tecnológicas e ganhos de eficiência produtiva
O foco das pesquisas de Hungria está na substituição parcial ou total de fertilizantes químicos por microrganismos com funções específicas, como fixação biológica de nitrogênio, síntese de fitormônios e solubilização de fosfatos. Essas soluções permitem aumentar a produtividade com menor uso de insumos, alinhando-se ao conceito de produzir mais com menos recursos naturais.
Um dos avanços mais relevantes foi a comprovação de que a inoculação anual da soja com bactérias do gênero Bradyrhizobium pode elevar em cerca de 8% a produtividade da soja, contrariando estudos anteriores de países como EUA, Austrália e Europa. Ainda mais significativo é o fato de que altos rendimentos podem ser alcançados sem aplicação de fertilizantes nitrogenados, o que reforça a viabilidade agronômica e econômica da tecnologia. Atualmente, cerca de 85% da área de soja no Brasil utiliza essa prática.
Outro marco foi o lançamento, em 2014, da tecnologia de coinoculação da soja, combinando Bradyrhizobium e Azospirillum brasilense. Essa inovação promove ganhos adicionais em desenvolvimento vegetal e produtividade. Em pouco mais de uma década, a coinoculação passou a ser adotada em aproximadamente 35% da área cultivada de soja, demonstrando alta aceitação no campo e impacto direto na eficiência produtiva.
Impactos econômicos e ambientais na escala do agronegócio
A adoção de tecnologias baseadas em biológicos tem gerado impactos expressivos. Em 2025, a economia estimada com a substituição de fertilizantes nitrogenados foi de aproximadamente 25 bilhões de dólares, evidenciando o potencial de redução de custos para o produtor rural. Esse resultado reforça a competitividade do agronegócio brasileiro no cenário internacional, especialmente diante da volatilidade dos preços de insumos químicos.
Do ponto de vista ambiental, os benefícios são igualmente relevantes. Em 2024, o uso dessas tecnologias permitiu evitar a emissão de mais de 230 milhões de toneladas de CO₂ equivalente, contribuindo para a mitigação das mudanças climáticas. A redução do uso de fertilizantes nitrogenados também diminui a poluição do solo e da água, reforçando o papel da agricultura como agente de sustentabilidade.
Além disso, o uso de microrganismos promove a saúde do solo, aumentando sua fertilidade e capacidade de retenção de água. Esse fator é essencial para a resiliência dos sistemas produtivos diante de eventos climáticos extremos. Assim, os biológicos se consolidam como ferramentas estratégicas para uma agricultura de baixo carbono e alta eficiência.
Expansão tecnológica e protagonismo global do Brasil
Os avanços obtidos com a soja também se estendem a outras culturas. Tecnologias envolvendo rizóbios e coinoculação foram recomendadas para o feijoeiro, enquanto o uso de Azospirillum brasilense tem sido aplicado em milho, trigo e pastagens. Em 2021, foi lançada uma tecnologia que permite reduzir em até 25% a adubação nitrogenada no milho, gerando benefícios econômicos e ambientais relevantes.

impulsiona inovação agrícola sustentável
Em sistemas de pastagens, especialmente com braquiárias, os biológicos contribuem para aumentar a produtividade e a sustentabilidade, reduzindo a necessidade de expansão de áreas agrícolas. Esse aspecto é estratégico para o Brasil, que busca intensificar a produção sem ampliar o desmatamento, alinhando-se às exigências globais de sustentabilidade.
O reconhecimento internacional de Hungria, incluindo premiações como o World Food Prize e sua presença em rankings científicos globais, reforça o protagonismo do Brasil na área de insumos biológicos e agricultura sustentável. A cientista também integra academias científicas e participa de organizações como a Sociedade Brasileira de Ciência do Solo, consolidando sua influência no desenvolvimento científico.
Perspectivas para a agricultura regenerativa e inovação sustentável
A crescente demanda global por alimentos de qualidade, aliada à necessidade de reduzir impactos ambientais, impulsiona a adoção de novos modelos produtivos. Conceitos como ESG, agricultura regenerativa e saúde única passam a orientar políticas e estratégias no agronegócio. Nesse contexto, os biológicos assumem papel central na transição para sistemas mais sustentáveis.
A abordagem defendida por Hungria baseia-se na produção com menos insumos, menos água, menos terra e menor impacto ambiental, sem comprometer a produtividade. Essa visão está alinhada às demandas de mercados internacionais e consumidores cada vez mais atentos à origem dos alimentos e aos métodos de produção.
O reconhecimento global da cientista evidencia que o Brasil possui capacidade técnica para liderar essa transformação. A continuidade desse protagonismo dependerá de investimentos consistentes em pesquisa, inovação e transferência de tecnologia, garantindo que os avanços científicos sejam efetivamente incorporados pelo setor produtivo e ampliem a competitividade do agronegócio nacional.






